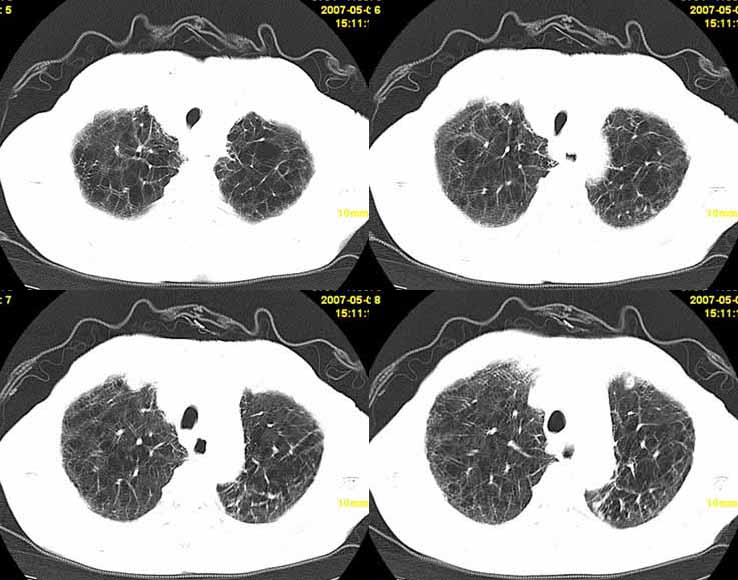
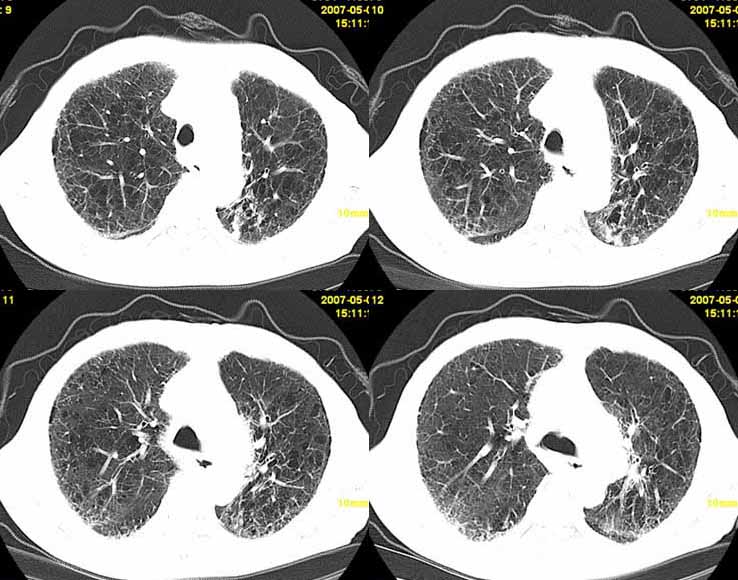

以下是引用小初学者在2007-5-12 11:09:00的发言:[br][br]双肺弥漫性质纤维化(考虑矽肺所致),并发左肺下叶背段周围性肺癌纵隔淋巴转移。
以下是引用zhangzhongshou在2007-5-12 12:09:00的发言:[br]1、左下叶背段周围型肺癌左肺门及纵隔淋巴结转移可能性大。[br]2、弥漫性肺气肿(双侧)。[br]3、双肺间质纤维化。
以下是引用zhangzhongshou在2007-5-12 12:09:00的发言:[br]1、左下叶背段周围型肺癌左肺门及纵隔淋巴结转移可能性大。[br]2、弥漫性肺气肿(双侧)。[br]3、双肺间质纤维化。
以下是引用老爱克斯新网客在2007-5-12 12:54:00的发言:[br]1周围型肺癌纵隔肺门淋巴结转移,2肺间质纤维化,
| 欢迎光临 医影在线 (http://bbs.radida.com/bbs/) | Powered by Discuz! X3.2 |